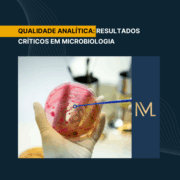

QUALIDADE ANALÍTICA: Resultados Críticos em Microbiologia
No laboratório clínico, alguns resultados simplesmente não podem esperar. Em especial na microbiologia, eles representam situações em que o intervalo entre o diagnóstico e a conduta médica pode, literalmente, definir o desfecho do paciente. Por isso, esses são chamados de resultados críticos — achados laboratoriais que indicam risco de morte ou necessidade de intervenção imediata, o que torna essencial uma comunicação rápida, um registro rastreável e profissionais devidamente preparados.
Além disso, eles funcionam como um indicador direto tanto da qualidade analítica quanto da pós-analítica, refletindo a eficiência e a responsabilidade do laboratório em cada etapa do processo.

Resultados críticos na microbiologia
O que são resultados críticos?
De acordo com a Sociedade Brasileira de Patologia Clínica/Medicina Laboratorial (SBPC/ML), resultados críticos são aqueles que, por si só, podem estar relacionados a situações clínicas potencialmente graves, devendo ser imediatamente comunicados ao médico solicitante.
O College of American Pathologists (CAP) reforça esse conceito: são resultados que exigem atenção clínica imediata para evitar a mortalidade do paciente. De forma complementar, segundo a RDC vigente, todos os resultados críticos devem ser notificados sem demora, com registro formal da comunicação, garantindo assim a rastreabilidade e a segurança no processo de informação entre o laboratório e o profissional solicitante.
Prazos recomendados para comunicação de resultados críticos
A rapidez na resposta faz parte essencial do controle de qualidade no setor de microbiologia, pois está diretamente relacionada à segurança e à efetividade do cuidado ao paciente. Nesse contexto, as recomendações são claras:
- Pacientes ambulatoriais: o ideal é que a comunicação ocorra em até 2 horas, não ultrapassando 6 horas em nenhuma hipótese.
- Pacientes internados: o profissional deve realizar a notificação em até 30 minutos após a liberação do resultado.
Além disso, a meta é alcançar 100% de comunicações bem-sucedidas, utilizando indicadores de desempenho para monitorar o processo e implementando ações corretivas sempre que houver falhas. Dessa forma, o laboratório garante agilidade, rastreabilidade e comprometimento com a qualidade assistencial.
Exemplos de Resultados Críticos em Microbiologia
Críticos (urgentes):
- Hemocultura positiva
- Isolamento de Neisseria meningitidis em líquor
- Klebsiella pneumoniae produtora de KPC
- Enterococcus faecalis resistente à vancomicina (VRE)
- Presença de Bacillus anthracis, Brucella spp., Francisella tularensis, Clostridium septicum
Semicríticos (semiurgentes):
- Cultura positiva para Salmonella spp., Shigella spp., Campylobacter
- Pesquisa positiva para toxina de C. difficile
- Detecção de microrganismos multirresistentes (MDR, KPC, NDM, VIM, etc.)
O papel da qualidade laboratorial com os resultados críticos na microbiologia
Para que um resultado crítico cumpra sua função, a qualidade deve estar presente em todas as etapas — desde a coleta até a comunicação final:
- Procedimento documentado (POP): definir claramente quais resultados são críticos e semicríticos.
- Formulário de comunicação: incluir data, hora, número do exame, resultado, destinatário, e responsável pela comunicação.
- Verificação e rastreabilidade: o analista deve confirmar a identidade do microrganismo e revisar controles internos antes da notificação.
- Indicadores de tempo: monitorar mensalmente o tempo entre o conhecimento do resultado e a comunicação efetiva.
- Segurança na comunicação: se for por telefone, solicitar que o receptor repita a informação para evitar interpretações erradas.
- Treinamento contínuo: todos os colaboradores devem saber quando e como agir diante de um resultado crítico.
A importância da gestão e da rastreabilidade
A gestão da qualidade garante que a informação chegue de forma confiável e rastreável. Um atraso de minutos ou uma comunicação incompleta pode comprometer o tratamento, principalmente em casos como meningites, septicemias e infecções por microrganismos multirresistentes.
Portanto, controlar, auditar e aperfeiçoar continuamente esse processo é essencial para a segurança do paciente e a credibilidade do laboratório.
Conclusão
Para o analista clínico, reconhecer a importância dos resultados críticos é atuar muito além da bancada — é compreender que cada cultura positiva e cada notificação imediata podem representar uma vida salva. Afinal, em microbiologia, qualidade significa assegurar respostas confiáveis, rápidas e seguras, traduzindo o compromisso do laboratório com a precisão diagnóstica e, acima de tudo, com a segurança do paciente.
Pós-Graduação em Qualidade Analítica e Gestão Da Qualidade Laboratorial
A pós em qualidade é um programa altamente especializado, projetado para capacitar profissionais da área da saúde que desejam aprimorar suas habilidades em gerenciamento laboratorial, gestão e garantia da qualidade, análise de processos e liderança de equipes. Para aqueles que procuram a comodidade de uma pós-graduação 100% online e ao vivo, sem abdicar da excelência no ensino, temos a solução ideal. Nossa metodologia combina teoria e prática da rotina laboratorial, garantindo um aprendizado efetivo.
Contamos com um corpo docente altamente qualificado, com os melhores professores do Brasil, referências em suas áreas de atuação. No Instituto Nacional de Medicina Laboratorial, temos apenas um objetivo: mais do que ensinar, vamos tornar VOCÊ uma referência.
Toque no botão abaixo e conheça a pós-graduação em Hematologia Laboratorial e Clínica.
QUERO CONHECER TODOS OS DETALHES DA PÓS-GRADUAÇÃO
Referências:
OPLUSTIL, Carmen Paz; ZOCCOLI, Cássia Maria; TOBOUTI, Nina Reiko; SCHEFFER, Mara Cristina. Procedimentos básicos em microbiologia clínica. 4. ed. São Paulo: Editora Sarvier, 2016.